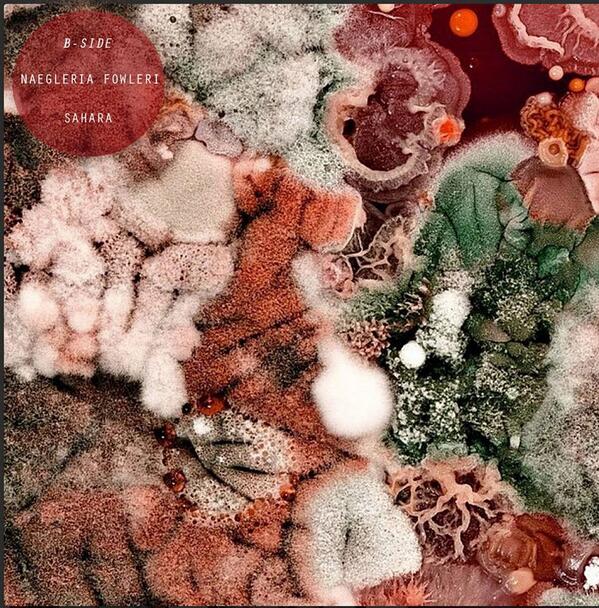
Sahara tweet media

Sahara retweetledi
Sahara
19 posts


Sahara
@SaharaUK
https://t.co/Ge68Fi9z9U https://t.co/D3iK8gvsbR
Katılım Şubat 2013
385 Takip Edilen99 Takipçiler
Sahara retweetledi

@Charolettecjozu sorry, we're a band. Product review isn't really our forte.. X
English

We haven't updated our Twitter for a while so you might have missed some great artwork done by @edielawrence.. Check it out now though!
English
Sahara retweetledi